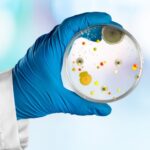

OFS
The Akbar Associates Oil Field Services (OFS) Division offers various services categorized into five core areas: Data Analytics, Conventional Studies, Dry or Under-Performing Well Postmortem, Onsite Services, and Geoscience Services.

Driving Excellence in Oil Field Solutions Innovatively!
Akbar’s Oil Field Services - OFS Division combines the strengths, knowledge, and experience of its oilfield service arm Petrolog, which has provided onsite wellhead completion, corrosion monitoring, and drilling engineering services to the local industry since 1986 and the reservoir engineering and the geoscience group constituted in 2015.
OFS Division now offers onsite and offsite services that can broadly be grouped into the following five categories.
- Data Analytics:
This is a journey towards digital dexterity that can elevate an E&P operation into an integrated, information-driven environment, improving oilfield safety, planning, productivity, and efficiency while at the same time mitigating risks and reducing costs.
- Conventional Studies:
Utilizing top-ranked interpretation software platforms to study geology, geophysics, petrophysics, drilling, and reservoir engineers, coupled with our highly qualified team of reservoir engineers, petroleum geologists, geophysicists, and petrophysicists, Akbar OFS offers a comprehensive relook and reassessment of a wildcat, new, developing inventories in both conventional and unconventional plays.
- Well Postmortem – Dry or Under-Performing:
For the first time in Pakistan, we offer Dry or Under-Performing Well Postmortem, Which is a comprehensive all-discipline study with a specific focus on searching for and identifying Knowledge Limitations, Model Deficiencies, and/or Data Inaccuracies utilizing all tools, including software and integrated data analytics.
- Onsite Services:
Onsite services include:
- Provision of qualified engineers and field staff for designing and installing corrosion monitoring and prevention equipment, including inhibition chemicals.
- Provision of qualified engineers and technicians for optimizing drilling operations, including drilling fluid rheology.
- Provision of engineering assistance and field supervision for wellhead completion.
- Geoscience:
By coupling our highly qualified team of geoscientists with IHS KINGDOM software for geology, geophysics, petrophysics, and analytics, Akbar Associates OFS Division has the capabilities to provide interpretation services for Geology, Geophysics, Petrophysics, Drilling Optimization, and Well Postmortem.

GEOLOGY
- Allows Structural & Stratigraphic Interpretation for Regional exploration, Well-Planned/Design, Geosteering & Field Management.
- Creation of Multiple Cross Sections, Manipulation of Formation Tops with or without Seismic Overlays, Perforations & Production Data.
- Conduct Basin-Wide Exploration & Development.
GEOPHYSICS
- Visualization & Interpretation of 2D and 3D Seismic Data, Pre-Stack Gather Data & Microseismic Data.
- Interpreting Faults & Fractures and identifying Geobodies.
- High Definition Velocity Modeling with Uncertainty Estimation.
- Subsurface Map Creation & Well Plan updating using Dynamic Depth Conversion.
- 1D and 2D Synthetic Modeling.
DRILLING OPTIMIZATION
- Structural Mapping: Accommodating new field information in real-time for structural maps, allowing for minimizing costs.
- Geological Prognosis Generation: Location optimal geologic position for each structure being drilled through.
- Geosteering: Consistent Subsurface Model to ensure an optimal portion of the subsurface for the greatest production.
- Completion Optimization: Well-Length Perforation Methodology, Pump Material & Acid Specification.
- Land Clearing Process: Quick Interpretation of Data to Plan Wells Efficiently for a better return on investment.
- Dynamic Depth Conversion: Velocity Model Creation using Well & Seismic Data.
- Geophysical Prospecting Workflows: Identify & Locate Viable Reservoirs & Reservoir Characterization Workflows.


PETROPHYSICS
- Regional Interpretation & Mapping using Digital Log Computations.
- Creation of Composite Logs for Interpretive Lithology & Cross Sections.
- Map Reservoir Properties Calculations: Water Saturation, Porosity & Permeability.
- Trend Calculation & Interactive Bulk Depth Shift Calculation.
WELL POSTMORTEM
- Comprehensive Re-Evaluation of Geological & Reservoir Models, including Well-Design and Drilling Methodologies, to Ζdentify Model Deficiencies and Inaccuracies that Led to the Absence of Hydrocarbons and Well-Failure.
- Well Postmortem is Different from End-ofWell Reports because they focus on searching and identifying Knowledge Limitations and Data Inaccuracies.
Microbial Testing & Detection
The same advanced microbial testing technology utilized by Akbar Associates for pathogen detection in water is also critical for the oil and gas sector. Microbial activity in wells can lead to corrosion, posing significant operational and safety risks. Akbar Associates and its partners provide comprehensive solutions to prevent such issues by testing for microbial buildup within wells. Using cutting-edge testing methods, we enable early detection and monitoring of harmful microbial activity, helping to mitigate corrosion risks and enhance the efficiency and longevity of oil and gas infrastructure. This integration of technology and expertise underscores our commitment to addressing diverse industry needs with innovative and reliable solutions.

Pioneering hydrocarbon microsleep detection
Using aerial technology, our solution locates pressurized reservoirs using planes outfitted with proprietary hydrocarbon sensors. By collecting, analyzing, and mapping microseeps, the solution can identify high-potential local areas revealing hidden reserves ahead of any seismic surveys or drilling, allowing for targeted seismic programs and fewer dry holes being drilled. This means higher success ratios, higher profits, and a lower per-barrel finding cost. The Airborne Hydrocarbon Sensing System (AHSS) concentrates and measures hydrocarbons from reservoir microseeps, presenting data in plan view maps for both oil and gas over the gridded project area. This information is combined with geological and geophysical data to determine trap type and depth, applicable both onshore and offshore. Rice Alliance.

Pioneering hydrocarbon microsleep detection
Using aerial technology, our solution locates pressurized reservoirs using planes outfitted with proprietary hydrocarbon sensors. By collecting, analyzing, and mapping microseeps, the solution can identify high-potential local areas revealing hidden reserves ahead of any seismic surveys or drilling, allowing for targeted seismic programs and fewer dry holes being drilled. This means higher success ratios, higher profits, and a lower per-barrel finding cost. The Airborne Hydrocarbon Sensing System (AHSS) concentrates and measures hydrocarbons from reservoir microseeps, presenting data in plan view maps for both oil and gas over the gridded project area. This information is combined with geological and geophysical data to determine trap type and depth, applicable both onshore and offshore. Rice Alliance.
AI Co-Pilot For Highly Regulated & Complex Engineering Environments
Process Engineers want to improve key performance indicators, unfortunately, the tools most engineers use today haven’t kept up with the market demand for productivity and speed. With Basetwo & Akbar Associates solution, engineers can use AI to rapidly simulate and optimize their processes.
- Rapidly Simulate & Optimize Processes: Optimized scale up, allowing you to learn how your process would perform at larger scales. As well as Real-Time Optimization, in order to discover the best way to operate your commercial-scale plant.
- Making Process Optimization Easy & Scalable: This solution has demonstrated to rapidly save corporations and manufacturers up to 44% on costs despite limited data availability.
- Optimize & Decrease Operational Costs: This solution has also enabled upstream drilling rigs to reduce diesel fuel consumption by 12-30%. This was done by helping drilling rig sites to optimize genset schedules and forecast drilling loads to improve real-time visibility and reduce costs by optimizing process controls.
- Engineering-Centric AI Platform: Capable of solving design & operations use cases across the heavy industry. Understanding of heavily regulated industries and provides the opportunity to build domain-specific solutions.
- Flexible SaaS Model: This solution provides a flexible Software as a Service model focused on demonstrating value.
